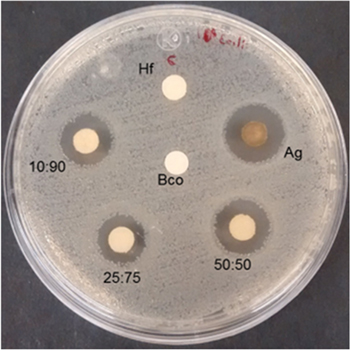
Figure 9.

Abstract
This work demonstrates an efficient, low-cost and environmentally friendly synthetic method of Ag/Cu bimetallic nanoparticles (NPs), which allows taking advantage of renewable resources, using Ricinus Communis leaf extract as bioreducing and passivating agent. By varying the metal salt precursors of AgNO3 and CuSO4.5H2O concentrations, the stable bimetallic NPs were obtained. The Ag/Cu bimetallic NPs were characterised using ultraviolet-visible absorption spectroscopy (UV–vis), Fourier-transform infrared spectroscopy (FTIR), X-ray dispersive energy spectroscopy (EDS), and scanning and transmission electron microscopy (SEM and TEM). In all cases, the particles size is less than 100 nm. The 10:90 Ag/Cu system has the best control of morphology (spheroid) and size in range of 10–25 nm ( σ = 9). Selected area electron diffraction patterns (SAED) are in concordance with JCPDF cards for silver and copper face-centered cubic (fcc) crystal structures. Microbiological susceptibility was tested by disc diffusion, minimum inhibitory concentration (MIC) and minimal lethal concentration (MLC) methods, with the following microorganism strains: Staphylococcus aureus (gram +), Escherichia coli (gram −) and Aspergillus niger (fungus). The MIC concentration for the three strains was found to range from 1.25 to 2.45 μg and the MLC allowance ranges from 2.45 to 9.81 μg.
σ = 9). Selected area electron diffraction patterns (SAED) are in concordance with JCPDF cards for silver and copper face-centered cubic (fcc) crystal structures. Microbiological susceptibility was tested by disc diffusion, minimum inhibitory concentration (MIC) and minimal lethal concentration (MLC) methods, with the following microorganism strains: Staphylococcus aureus (gram +), Escherichia coli (gram −) and Aspergillus niger (fungus). The MIC concentration for the three strains was found to range from 1.25 to 2.45 μg and the MLC allowance ranges from 2.45 to 9.81 μg.
Export citation and abstract BibTeX RIS
1. Introduction
Nanostructured metallic materials have been of great interest because the control of their size, distribution, structure, morphology and medium composition, allows absorbing and dispersing the energy of the medium in a different way compared to that in microscopic materials, changing drastically physical, chemical, mechanical, magnetic, biological, optical, electrical, physicochemical and catalytic properties [1, 2]. This allows the design of materials for specific needs, which reduces the necessary material and demanded energy. It has potential applications in various areas of study and industrial processes such as chemistry, biology, medicine, health, biomedical science, catalysis, electronics, environment, cosmetics, industrial foods, among others [1, 3–6].
Several physical, chemical and biological synthetic methods have been studied to control nanoparticles (NPs) properties [7–10]. Following the principles and philosophy of green chemistry, methods and procedures focus on the use of biological material to maximise resources, reduce or eliminate the use of dangerous reagents, pollution, generation of hazardous substances and toxic waste in more environmentally friendly processes [11–18]; biomass such as bacteria, fungi, tree components, shrubs, and their fruits or extracts are used to carry out the bioreduction [6, 7, 19–24]. The synthesis of metal NPs using diverse plant aqueous extracts as reducing agents has been the main methodology employed so far [25]. It is, usually, a straightforward method; the kinetics of this bioreduction reaction can be easily monitored by UV–vis spectroscopy, throughout the surface plasmon resonance. Perhaps the only disadvantage of this method is the polydispersity of the obtained NPs and their different morphology that appears with some bioreducing agents. However, these latter characteristics of NPs are not so important in several metal NPs applications, such as sensing [26] and antibacterial properties [27]. Recently, the interest has been devoted to research on biomedical applications such as empowered antimicrobial [28] and anticancer [29] properties of biogenic metal NPs, where the main appeal is related to the facile and green synthetic methodology, and to the possible synergic interactions between the metal nanoparticle and the surrounding biomolecules, coming from the reducing agent precursors. In this context, the present synthesis focuses on the use of aqueous leaf extract of Ricinus communis (R. communis) as a reductant and passivating agent, since it contains bioactive constituents such as alcohols, amino acids, proteins, lactones, terpenoids, flavonoids, among others that can perform well these roles [6, 30–32].
Noble metals microbiological properties have been extensively investigated. Specifically, noble metals NPs have shown superior antimicrobial action than their bulk form [33]. Particularly, Ag NPs [4, 20–22, 34–37] have been demonstrated to exhibit stability, conductivity, catalytic activity, antibacterial, antiviral, antifungal, anti-inflammatory properties [4, 5, 38]. Ag and its compounds with other metals such as Cu [30, 33, 39] are of interest because they combine the properties of different elements, enhancing the characteristics of the Ag-Cu material [14, 17, 18, 33, 38, 40], also, the lower price of Cu reduces the cost, making cheaper materials and processes. Ag NPs have been obtained through the extract of R. communis [5, 6] that in India is used in the traditional health area, in Mexico the seed is exploited to obtain the castor oil [41–43] and is considered a pest, so the synthesis of bimetallic Ag/Cu NPs presents an opportunity to exploit natural resources.
Herein, bimetallic Ag/Cu NPs were synthesised throughout an easy, low-cost and green methodology, using R. Communis leaf aqueous extract as reducing agent. Moreover, the antibacterial and antifungal properties of Ag/Cu NPs, with different compositions, were evaluated.
2. Experimental
2.1. R. communis leaf aqueous extract preparation
R. communis leaves were collected in the Tenancingo de Degollado, State of Mexico, Mexico. They were washed with abundant water and then several times with deionised water. Next, they were placed to sun-dry on watch glasses with filter paper and then the dried leaves were cut into little pieces. 10 g of these leaves was added to 100 ml of deionised water and boiled for 5 min. Next, they were cooled at room temperature and filtered to obtain the aqueous extract. A 1/10 dilution of the aqueous extract was used for the synthesis.
2.2. Biosynthesis of bimetallic Ag/Cu NPs
10 mM solutions of silver nitrate (AgNO3) and copper sulfate (CuSO4.5H2O) were prepared with Ag/Cu volume ratios of 10:90, 25:75 and 50:50. The corresponding Ag/Cu precursor solution and 10 ml of R. communis extract (1/10) were mixed in 1 ml vials. The solutions became grayish over time.
2.3. Characterisation studies
NPs biosynthesis was monitored for six hours by scan of maximum absorption wavelength of 280–800 nm in a UV–vis Cary 100 spectrophotometer. Double beam correction and zero baseline of the spectrum were made placing the aqueous extract of R. communis (1/10), used in the synthesis, in the cell reference. Fourier-transform infrared (FTIR) spectra were obtained with a Prestige-21 Shimadzu infrared spectrophotometer with a scan of 4000 to 500 cm−1. Drops of the samples were placed in a glass slide and dried to place the powder in the sample holder.
The size, morphology and composition of the bimetallic NPs were studied by a 200 kV JEOL 2100 transmission electron microscope (TEM) with LaB6 filament and scanning electron microscopy (SEM) in a JEOL JSM-6510LV microscope equipped with an elementary microanalysis system. For TEM measurement, the samples were sonicated for 15 min. Next, these samples were separated and cleaned by centrifugation for 15 min at 9000 rpm, followed by decanting and re-dispersing in deionised water for washing on several occasions. The images were analysed with the program 'Image J'. For SEM, the samples were sonicated for 5 min and drops were placed on double-sided carbon tape over metal slide.
All microbiological manipulations were performed inside the laminar flow cabinet. Antibacterial activity was evaluated in strains of S. aureus ATCC25293 and E. coli ATCC25922, seeded in test tubes with BHI (Brain Heart Infusion) agar medium and EMB (Eosin Methylene Blue) agar respectively incubated at 38 °C for 48 h, antifungal activity was evaluated with a strain of A. niger in PDA (Potato Dextrose Agar) culture medium incubated at 25 °C for 48 h. The colonies were taken from Petri dishes seeded in same conditions
For disc diffusion test (inhibitory halo), a seeded colony in a Petri dish of the E. coli strain ATCC25922 was taken, with sterile saline solution and UV–vis spectrophotometer at 625 nm it was equal to turbidity standard 0.5 McFarland (1 × 108 UFC ml−1). The inoculum was rolled on a Petri dish with MH (Müeller-Hinton) agar and allowed to dry. Whatman No. 42, 6 mm filter paper discs impregnated with NPs (15-min sonication in the vials with NPs and allowed to dry) are placed on the Petri dish and incubated at 36 °C for 48 h to observe and measure the halo.
2.3.1. Minimum inhibitory concentration (MIC)
Sterile treated multiple polystyrene well plates with 8 × 12 (96) with work capacity of 200 μl/well were used. In the second column of the plate an aliquot of 200 μl of NPs was placed and 100 μl of MH culture broth was added in the rest of the wells. NPs were diluted consecutively to 50% with a 100 μl pipette taking an aliquot of the NPs well and diluting it in the right well, continuing subsequently to column 11 (leaving only 100 μl) the last column on the right only with culture broth. An aliquot of each preparation with microorganism to be evaluated was prepared and was taken from 1 × 108 CFU ml−1 (0.5 McFarland) concentration to 1 × 106 CFU ml−1, pouring 100 μl into each well from the one containing the undiluted NPs until the last to have a final concentration of 5 × 105 CFU ml−1. The plate was closed and incubated according to the microorganism. The test is valid if the first column with culture broth remains translucent and the last column is turbid.
2.3.2. Minimal lethal concentration (MLC)
Subcultures of the MIC ware made. A Petri dish with MH agar was divided into six sections: a blank (takes nothing), control (column 12 of the MIC boxes that is the broth and microbial culture) and in the rest a small drop of the wells was placed where there was no turbidity for each sample of NPs. It was incubated according to the previous specifications. The test is valid if there is no growth in the target and there is growth in the control; for the samples taken from the MIC, the MLC was the one where there was no growth.
3. Results and discussion
3.1. UV–vis absorbance spectroscopy
NPs were obtained from R. comunis extract in proportion ((1/10) 1 ml of extract and 9 ml of deionised water) and 10 mM precursor solutions of Ag/Cu 10:90, 25:75 and 50:50. When the extract was added, solutions turned to a yellow-brown colour, which intensified slowly as time elapsed, as shown in figure 1, which indicates the metal ion reduction and the NPs formation.
Figure 1. Photograph of NPs synthesised with R. communis aqueous (1/10) extract and mixture solutions of (CuSO4) and Ag (AgNO3) with volume ratios of Ag:Cu of 10:90, 25:75, 50:50, at 15 min and 3 h. Rc (R. comminis extract 1/10).
Download figure:
Standard image High-resolution imageUV–vis spectra show the corresponding surface resonance plasmon (SPR) at peaks from 407 to 442 nm and the absorption intensity increases with the Ag concentration in the system, as seen in the spectra at 6 h for samples Ag/Cu of 10:90, 25:75, 50:50 and 5 min for Ag (figure 2). It shows that in Ag/Cu systems the range of 480–800 nm increases absorbance too, which does not occur in Ag NPs, which indicates formation of particles of different compositions or sizes for samples with ratios of 25:75, 50:50; Ag NPs spectrum in 442 nm and image show that it reduction is faster and concordant with spherical NPs reported to Ag [5, 6].
Figure 2. UV–vis spectra of Ag/Cu systems at 6 h and Ag NPs at 5 min.
Download figure:
Standard image High-resolution imageA UV–vis cell of 25:75 system sample was monitored for 20 h to see the maximum absorbance that was 15 h as seen in the figure 3, 16–24 h signals in green remained stable.
Figure 3. UV–vis spectra of Ag/Cu 50:50 system from 5 min to 20 h.
Download figure:
Standard image High-resolution image3.2. FTIR analysis
The FTIR spectrum signals from the extract of the R. communis leaf in figure 4 (black line) are identified as follows. The band at 3286 cm−1 corresponds to O–H stretching for the H associated with sugars, phenols and alcohols [6]. Bands between 2993 and 2850 cm−1 correspond to C–H stretching of hydrocarbon chains. In 1747 cm−1 the asymmetric stretching of NO2 is found. The signal at 1643 cm−1 corresponds to N–H bending primary amines. Signals at 1457 and 1373 cm−1 correspond to C–H stretching. The band on 1318 cm−1 corresponds to O–H bending and the bands at 1266 and 1046 cm−1 can be attributed to ether linkages [5].
Figure 4. FTIR spectra of R. communis (HF-black line), Ag/Cu 10:90 (red), 25:75 (green), 50:50 (navy blue) and Ag NPs (blue).
Download figure:
Standard image High-resolution imageIn FITR the signals assigned to the terpenoids used for the biosynthesis of Ag NPs are: of 1636, 1608 and 1500 cm−1 to vibrations of elongation C=C of aromatic rings, 1432 cm−1 to OH deformations that traversed to 1382 cm−1 when forming Ag NPs, 1384 cm−1 to terminal methyl groups and the signals of 1300 cm−1 to 885 cm−1 to C–O stretching vibrations of alcohols, ethers and esters [31, 32], suggesting the presence of alcohols, ketones, aldehydes, lactones, terpenoids, flavonoids, amino acids and proteins absorbed on the surface via the interaction of π electrons or carbonyl groups, indicating that the biomolecule possibly performs the two functions of formation and stabilisation of NPs in the aqueous medium [6, 30–32].
The band around 1643 cm−1, with Ag NPs, is a discrete signal, in 10:90 rate it forms a more intense signal, when increasing the concentration of Ag (25:75 and 50:50) it is divided into two signals, each time more defined; the signal at 1266 cm−1 (R-O-R') widens and lengthens as the concentration of Ag increases in the Ag:Cu systems, suggesting that the signals are due to the interaction of the biomolecules in the extract and the metal particles formed.
3.3. SEM-EDS analysis
SEM analysis was carried out to see aggregates that form the particles and to analyse the chemical composition by EDS to evidence the presence of metals in the synthesised samples. Secondary electrons analysis micrographs in figure 5 allow us to observe the aggregate topography of nanoparticles. An increase of particles with greater brightness when increasing the concentration of silver in the systems, can be observed, these particles are embedded in the biomass of the synthesis.
Figure 5. SEM images of nanoparticles of: (a) Ag/Cu systems 10:90; (b) 25:75; (c) 50:50; (d) Ag.
Download figure:
Standard image High-resolution imageX-ray energy dispersion spectrometry (EDS) elemental analysis for Cu and Ag (figure 6 and table 1) shows the increase in Ag atomic percent concentration in the NPs, Ag concentration determined in the NPs is higher than the Ag ratio added to the systems: 10:90 (18:82), 25:75 (63:37) and 50:50 (87:13). It is reported that the decrease in the concentration of Cu can be due to the formation of NPs with Cu core and Ag shell or Ag/Cu NPs [44–46]. Another justification for these results is that Cu0 reduces Ag+ ions, forming Cu2+ ions in solution that are reduced again [45, 46] and are covered by Ag, the remaining Cu2+ is reduced in a large crystal of Cu0 [45].
Figure 6. EDS spectra for: (a) Ag/Cu 10:90, (b) 25:75, (c) 50:50 and (e) Ag NPs systems. Cu appears around 1 and Ag between 2.6 and 3.3 keV, respectively.
Download figure:
Standard image High-resolution imageTable 1. EDS atomic % for Ag and Ag/Cu systems.

|
3.4. TEM studies
TEM images show predominantly spherical shape for small particles and irregular form for larger particles. The 10:90 system (figure 7(a)) has an average size of 18 nm and σ = 9 nm (standard deviation) with predominant spherical form, the 25:75 system (figure 7(b)) has particles of average size of 64 nm and σ = 17 nm, 50:50 (figure 7(c)) has two representative samples with an average particle size of 7.8 nm and σ = 7.8 nm (less than 5 nm for 56%, 5–40 nm for 34% of total measured) and average particle size of 73 nm and σ = 10 nm (50–90 nm for 10% of total measured), Ag NPs (figure 7(d)) are in the range of 24 nm with σ = 9 nm, the 10:90 system presents particles with greater monodispersity, better control of size and morphology.
Figure 7. TEM images of: (a) 10:90 Ag/Cu, (b) 25:75 Ag/Cu, (c), 50:50 Ag/Cu and (d) Ag NPs.
Download figure:
Standard image High-resolution imageFigure 8 shows the selected area electron diffraction (SAED) pattern of the systems 10:90, 25:75 and Ag, the ring-like diffraction pattern indicates the crystallinity of the samples. The diffraction patterns can be indexed with diffraction cards 03-065-8428 of silver fcc structure and 01-070-3038 of copper fcc structure. The 10:90 system (figure 8(a)) shows the diffraction planes (220), (311) for the Cu fcc and (222), (400) (331), (311), (222) planes for silver fcc; in the 25:75 system (figure 8(b)) the crystalline planes (400) and (222) corresponding to the fcc silver and copper respectively are identified; figure 8(c) shows the (400) and (222) lattice planes for silver fcc.
Figure 8. SAED pattern of: (a) 10:90 Ag/Cu, (b) 25:75 Ag/Cu and (c) Ag NPs.
Download figure:
Standard image High-resolution image3.5. Disk diffusion test
The E. coli strain was used to test the antibacterial action of the NPs before performing the MIC and MLC tests; figure 9 shows the inhibition halos with radius of 3.6, 3.1, 2.5 and 2.9 mm around the discs impregnated with Ag, 50:50, 25:75 and 10:90 NPs systems, respectively; the disc impregnated with R. communis extract (1/10) does not present an inhibitory halo.
Figure 9. Inhibitory halo on Petri dish of E. coli strain for discs impregnated with R. communis extract (1/10) (Hf), Ag/Cu NPs systems with ratios of 10:90, 25:75 and 50:50.
Download figure:
Standard image High-resolution image3.6. MIC and MLC
The MIC tests were carried out in culture plates with 96 wells of 200 μl, with 100 μl of MH broth, the NPs and their successive dilutions at 50% were inoculated with the bacterial strains S. aureus (ATCC25293), E. coli (ATCC25922) and the fungus A. niger, incubated at 38 °C (bacteria) and 25 °C (fungus) for a period of 48 h. The results were corroborated by looking to that of the negative control (broth only), which did not have turbidity and the positive control (broth with the microbiological strain) which showed turbidity that indicates the growth of microorganisms. The MLC test was inoculated on Petri culture dishes divided into six sections inoculated with the samples of the MIC test without turbidity. The lack of growth in the section of the blank confirms no contamination and the growth of the section of the well 12 (broth and microbiological culture) confirms the adequate conditions for growth.
Table 2 shows that E. coli and A. niger MLC is the same as MIC except for the 50:50 sample where concentration is high. In S. aureus 10:90 do not present MLC, 25:75 and 50:50 have MLC concentrations twice their MIC, in silver the MLC is eight times higher than the MIC. Ag/Cu systems have higher concentrations of MIC and MLC than silver, except for MLC for S. aureus if it presents them (10:90 not present MLC). 10:90 presents silver concentration notoriously lower than the rest of the systems to generate inhibition and eliminate microorganisms (except S. aureus). R. communis extract (1/10) does not present antimicrobial activity. The results suggest that the antimicrobial sensitivity of the particles is a combination of the size, shape and composition of the particles.
Table 2. MIC and MLC for R. communis, Cu, Ag/Cu NPs systems 10:90, 25:75, 50:50.

|
4. Conclusions
R. communis aqueous leaf extract was used to reduce Ag and Cu ions in a biological and environmentally friendly method to generate Ag/Cu bimetallic NPs in a rapid and simple one-step green synthesis. The results show that the Ag and Cu volume ratio is relevant to control the size, form and composition of the bimetallic NPs, which also promotes their antimicrobial properties. The SAED pattern confirms the face-centered cubic crystalline structure for Ag and Cu. UV–vis and FTIR results suggest interaction between the biomolecules of extract and the synthesised NPs. The microbial properties of the 10:90 system, with particle size around 18 nm (σ = 9 nm) confirm that the synthetic method presents the advantages of a low-cost process that may have potential applications in medicine and technological applications.
Acknowledgments
F López-Ubaldo acknowledges CONACYT financial support to conduct postgraduate studies.